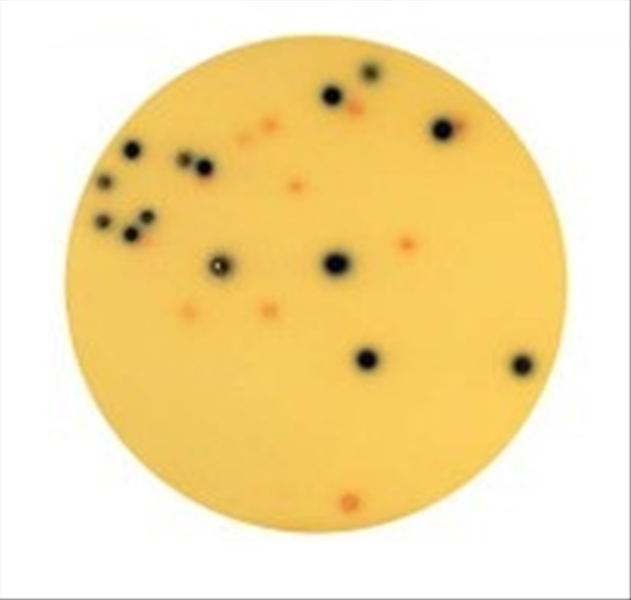

CHROMOGENIC COLIFORM AGAR 6X100ML
- Disponibilidad limitada
- Código: L032159
Usuario NO autorizado a proceder con la cotización.
Área reservada Añadir a favoritos
Usuario NO autorizado a proceder con la cotización.
Área reservada Añadir a favoritos